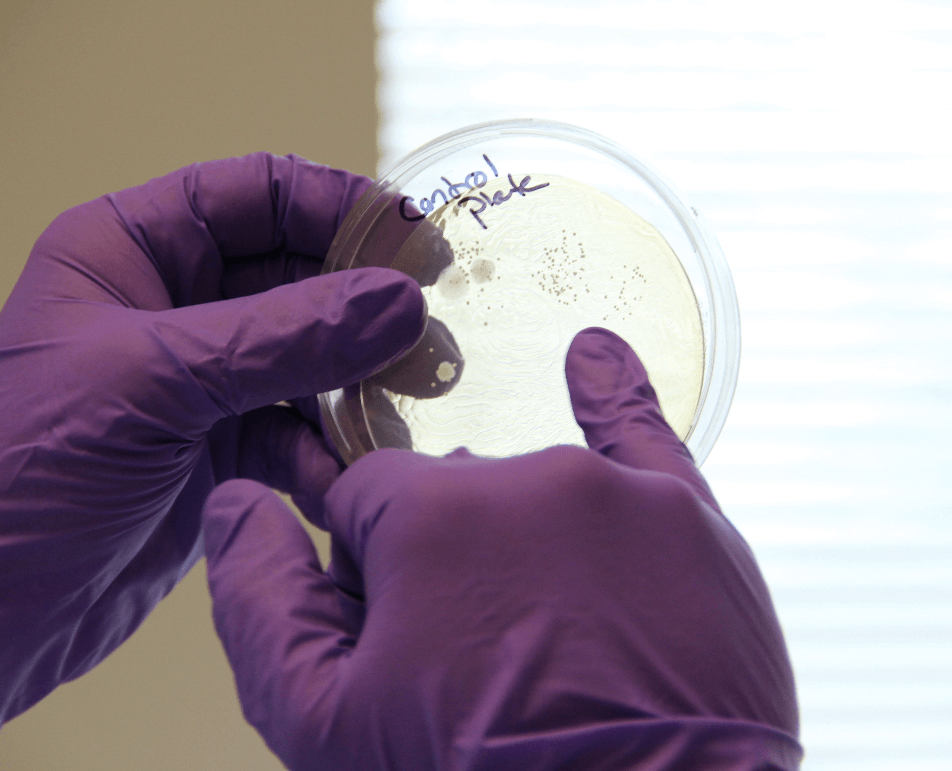

THE ISOVive STORY
ISOVive is made in collaboration with the top gastroenterologists, scientists and universities in the United States.

Overcoming Gut Health Challenges
ISOVive’s founders all had one thing in common: a health need that wasn’t being addressed by standard Western Medicine. After poring over the scientific literature, we learned that resolving imbalances in the gut’s microbiome can not only support better digestion but also better overall health.

What Does Sourdough Bread Have to do With Prebiotics?
We thought that we were eating a healthy diet rich in vegetables and whole grains, but it turns out something was still missing: a type of fermented prebiotic that used to be in the food supply when people made their own sourdough bread from ancient wheat. But today, with changes in wheat, that prebiotic is no longer available even in sourdough bread.

Starving Bacteria and Leaky Gut
Without that prebiotic, some of our gut bacteria are essentially starving, forcing them to consume the mucus lining of the colon to survive. These “chinks in the gut’s armor” lead to what is called “leaky gut syndrome,” a primary source of systemic inflammation. No wonder our health issues weren’t being resolved by the various “treatments”!

Microbiome Research
Researchers at one of America’s top universities were concurrently doing the same research and we were introduced to them. They gave us samples of ISOVive from the lab and that was when everything changed!
Unlocking the Healing Power of the Microbiome
We couldn’t keep this secret to ourselves. We needed to bring ISOVive and the benefits of prebiotics to the rest of the world. ISOVive is like NO OTHER prebiotic on the market today! We gathered a team of top digestive experts and researchers to make ISOVive the best possible product. Helping people feel better is what gets us up every morning. We hope you experience the same amazing positive health impacts we have gained from our daily dose of ISOVive Prebiotic Nectar.
